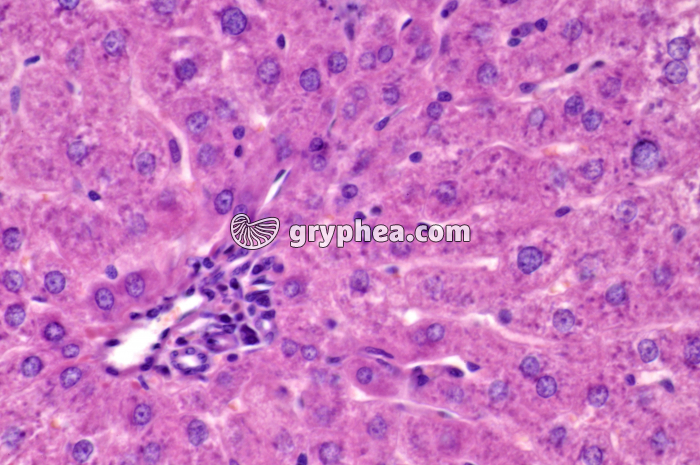
Foie x160 - gryphea.org

Les photographies, infographies, vidéos, sons et textes publiés sur ce site ne sont pas totalement libres de droits. Vous pouvez les utiliser librement à titre personnel, dans la création de vos cours, compte-rendus, diaporamas, en respectant le watermark qui y est inclus, à la condition expresse d'avoir souscrit à un abonnement. Le contrat d’utilisation ne vous autorise cependant pas à diffuser ces documents ailleurs que dans le cadre strict de votre enseignement, et en aucun cas sur les réseaux sociaux. Merci de votre compréhension.
Pour accéder à tous les contenus de gryphea.org, aux photos haute définition et aux vidéos intégrales, profitez de nos offres d'abonnement :
Organe annexe du tube digestif, le plus gros de tous les organes abdominaux, il est constitué de 2 lobes principaux, droit et gauche, et de 2 petits lobes annexes. On lui attribue plus de 300 fonctions vitales, dont les plus connues sont la sécrétion de la bile (dans la vésicule biliaire), des fonctions de stockage (principalement du glucose sous forme de glycogène et de vitamines hydrosolubles), de synthèse (glycogène, cholestérol, lipides, protéines du sang), de détoxification (transformation de l’ammoniaque sanguin toxique en urée, destruction des toxines et médicaments), de régulation (glycémie), et un rôle endocrine (synthèse d’hormones). Les cellules hépatiques (hépatocytes) sont organisées en lobules polyédriques disposés autour de vaisseaux et de canaux biliaires intrahépatiques. Ces lobules se distinguent facilement de leurs voisins par les travées de tissu conjonctif qui les séparent. Entre les hépatocytes, d’innombrables capillaires sanguins aux parois minces sont[...]
La suite du commentaire est réservée aux abonnés